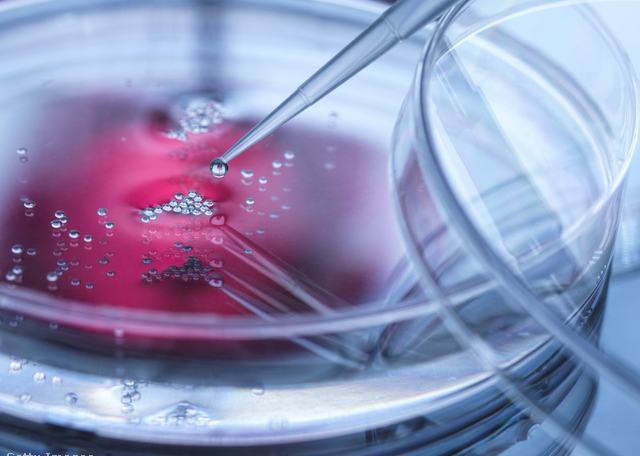

Mintegy 30 ezer közönséges makákó befogadására alkalmas komplexumot építene egy amerikai cég, a Safer Human Medicine. A majomvárost azért hoznák létre, hogy a tenyészteni kívánt állatokon egyetemek és gyógyszerkutató cégek állatkísérleteket végezzenek.
Majdnem egy teljes négyzetkilométeren terülne el az a majomváros, amelyet az amerikai Georgia államban található Bainbridge település mellett építenének föl. A komplexumban az elkövetkező húsz év alatt 30 ezer közönséges makákót tenyésztenének, hogy egyetemeket és gyógyszercégeket lássanak el kísérleti alanyokkal. Amennyiben a terv megvalósul, érdekes helyzet állhat elő a településen: több majom fog ott élni, mint ember, hiszen Bainbridge lakosainak a száma mindössze 14 ezer.
Nem lelkesednek a helyiek a majomvárosért
Bainbridge lakói azonban nincsenek elragadtatva ettől a tervtől. Helyi civil szervezetek már fel is szólították a hatóságokat, hogy ne engedélyezzék a komplexum megépítését.
![]()
Nem hiszem, hogy bárki szívesen lenne 30 ezer majom szomszédja
– mondta egy helyi lakos, akinek otthonától mindössze 400 méterre lenne a majomváros. Helyi hatóságok a lakosok felháborodására válaszul már szavaztak is arról, hogy visszavonják a tervezett épületegyüttesnek szánt tízéves adókedvezményt, ám ettől az építkezés még meg tud indulni, hiszen a szükséges engedélyeket már megszerezték.
A 396 millió dolláros projektet jegyző Safer Human Medicine válaszul nyílt levelet írt Bainbridge lakóinak. „Mindannyiunknak szüksége van ezekre a főemlősökre ahhoz, hogy meg tudjuk védeni magunkat és szeretteinket” – írták. A dokumentumot képekkel is feldobták, amelyeken napfényes apartmanokban különféle játékokkal szórakozó majmok láthatók.

Sok a vita az állatkísérletek körül
A tervezett majomváros ellen az állatvédők is felemelték a hangjukat. Ezek a szervezetek eleve elítélendőnek tartják, hogy csak azért tenyésszenek főemlősöket, hogy utána kísérleti alanyoknak használják őket. Ennek van is alapja: a legtöbb országban például emberszabású majmokon már tilos kísérleteket végezni. A világon elsőként Spanyolország kifejezetten jogokkal is felruházta az emberszabású majmokat: 2008-ban olyan jogi szabályozást hoztak, amelynek értelmében
ezeknek az állatoknak joguk van az élethez, a személyes szabadsághoz, és tilos őket kínozni.
Az Egyesült Államok azon országok egyike, ahol még szabad emberszabásúakon kísérletezni: több mint 1000 csimpánz él itt tudományos létesítményekben. Egyébként is a legnagyobb számban az USA-ban végeznek állatkísérleteket, az országban közel 70 ezer főemlőst tartanak ilyen célokra. (Összehasonlításképp: az egész Európai Unióban ez a szám összesen körülbelül 7000.) Ezzel a magas számmal indokolja a majomváros létrehozásának szükségességét a Safer Human Medicine is.
Állatkísérletek Magyarországon
Magyarországon a jelenleg érvényes jogi szabályozás szerint tilos állatkísérleteket végrehajtani emberszabású majmokon, kóbor, de háziasított állatfajokon (vagyis például kóbor kutyákon) és vadon befogott állatokon. A törvény tiltja azokat a kísérleteket is, amelyek súlyos, hosszan tartó fájdalommal járnak. Nem adható ki engedély szépítőszer, dohány- és egyéb élvezeti cikk vagy fegyver előállítása céljából tervezett kísérletre.
Régen jó okkal használtak állatokat
Természetesen az állatkísérletek hozzájárultak az idők során bizonyos egészségügyi problémák megoldásához, illetve a tudomány fejlődéséhez. Az 1940-es években például Jonas Salk rézuszmajmokon különítette el a járványos gyermekbénulást okozó poliovírus három formáját, amelyek akkoriban emberek százezreit nyomorították meg. Ezeknek a kísérleteknek a segítségével sikerült kifejleszteni a betegség elleni vakcinát, melynek hatására az ezt követő öt évben csak az USA-ban tizenötödére esett vissza a megbetegedések száma. Ugyancsak elengedhetetlenek voltak az állatokon végzett kísérletek az emberi agyféltekék funkcióinak felderítéséhez, a Parkinson-kór részleges kezeléséhez, illetve az AIDS gyógyításáért még mindig folyó harchoz.
Ki is lehet váltani az állatkísérleteket
Vannak azonban módszerek, amelyeket alkalmazni lehet állatkísérletek helyett. Bizonyos esetekben sejtkultúrákat növesztenek, és ezeken végzik el a beavatkozásokat. A sejtkultúrák növesztéséhez ugyanakkor állatembriókból nyert szérumra van szükség. Egyes számítások szerint minden évben mintegy egymillió tehénembriót pusztítanak el, hogy ezt a szérumot megfelelő mennyiségben elő tudják állítani. Bizonyos genetikai és molekuláris kutatásokhoz állatok helyett a Cunninghamella elegans nevű gombafajt is fel tudják használni a kutatók a gyógyszeranyagcsere vizsgálatára. A legfrissebb, és legfejlettebb módszer segítségével pedig háromdimenziós szerveket vagy szervrészeket növesztenek, és ezeket használják állatok helyett.
Ha szívesen olvasnál arról, hogy mi a tudomány és az állatvédők álláspontja az állatkísérletekkel kapcsolatban, kattints ide!
























